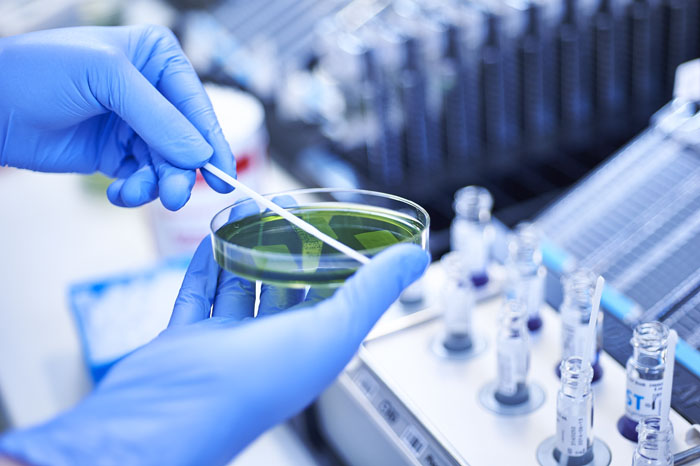
oderland1

Promocyjna oferta
W dniach 23.11.2016 - 16.12.2016 za wykonanie analiz pozwalających ocenić podstawowe funkcje organizmu zapłacimy tylko 15 EUR (rzeczywista wartość wg cennika to 35 EUR). Zestaw badań obejmuje:
- morfologię z rozmazem;
- poziom żelaza;
- wskaźniki stanu zapalnego: CRP;
- parametry cukrzycowe: glukoza, HbA1c;
- elekrolity: sód, potas, wapń, chlorki;
- gospodarkę tłuszczową: cholesterol, triglicerydy, HDL, LDL;
- badanie tarczycy: TSH;
- badanie wątroby: ALAT;
- badanie nerek: kreatynina, GFR, kwas moczowy;
- makroelementy: magnez.
Rejestracja
W celu sprawnej obsługi pacjentów uruchomiono rejestrację telefoniczną w godz. 8:00 -20:00, pod numerem telefonu 00 48 95 758 2649 (kontakt w języku polskim i niemieckim).

Badania dodatkowe
Instytut oferuje kompletne spektrum nowoczesnej diagnostyki laboratoryjnej, mikrobiologicznej, transfuzjologicznej oraz biologii molekularnej. Przy okazji skorzystania z promocyjnej oferty będzie możliwość pobrania materiału także w kierunku innych badań (nie znajdujących się w panelu promocyjnym). O zakres tych badań i ich odpłatność najlepiej zapytać bezpośrednio w Punkcie Pobrań IMD.
[reklama]